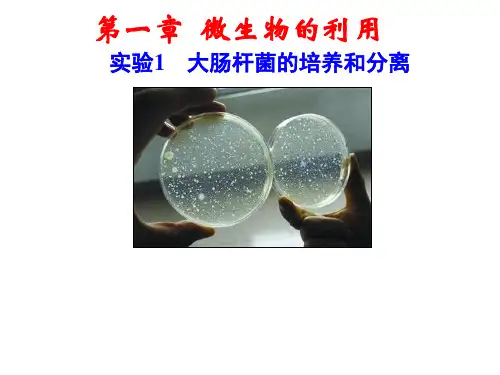

实验1-大肠杆菌的培养与分离
- 格式:ppt
- 大小:5.54 MB
- 文档页数:53


实验1 大肠杆菌的培养和别离高二年级班学号:实验日期:____月日【知识准备】1.背景知识:大肠杆菌〔Escherichia coli,E.coli〕是微生物学和遗传学常用的实验材料,为单细胞原核生物,宽约0.5×1~3微米;具有由肽聚糖组成的细胞壁;周身具鞭毛,能运动。
大肠杆菌是在人和动物肠道中生活的、不会致病的正常栖居菌,但假设进入胆囊、膀胱等处也会引起炎症。
它能利用多种糖类物质产酸、产气,其代谢类型为异养兼性厌氧型;其代谢活动能产生大肠杆菌素〔抑制肠道内其他分解蛋白质的微生物生长〕,还能合成维生素B和K。
它们在肠道中大量繁殖,几乎占粪便干重的1/3。
实验室中用于培养微生物的营养物质称为培养基。
按培养基的物理状态可分为:液体培养基和固体培养基。
将已知的菌种引入新配制的培养基的过程称为接种。
而在固体培养基外表用蘸有菌种的接种环连续划线,既可以到达接种的目的,又可以实现别离菌种的目的。
这是因为划线过程中接种环与培养基外表接触,接种环上的菌液逐渐减少,因此划线最后部分细菌间的距离加大,经过培养后可出现由单个细菌细胞形成单菌落,这样就到达了别离细菌的目的。
2.实验原理:使用通用的细菌培养基〔如LB液体培养基〕可扩大培养大肠杆菌,使大肠杆菌迅速扩增。
在LB固体平面培养基上对大肠杆菌进行划线别离,经培养后培养基上每一个菌体会形成一个单独的菌落。
这是消除污染杂菌的通用方法,也是用于筛选突变菌株的最简便方法之一。
为保证配制的培养基上只生长大肠杆菌,而不被其他微生物污染,实验过程中要进行无菌操作。
3.思考题〔1〕为什么培养过程中会出现被其他微生物污染的现象?〔2〕进行了无菌操作是否肯定就不会出现被其他微生物污染的现象吗?〔3〕本实验的关键步骤——划线别离的目的是什么?〔4〕在做第二次以及其后的划线操作时,为什么总是从上一次划线的末端开始划线?在操作过程中应注意什么?【实验目的】1.利用液体培养基进行大肠杆菌的扩增2.用固体平面培养基进行大肠杆菌的划线别离3.了解微生物实验的操作原理和培养条件【材料用具】大肠杆菌菌种装有固体培养基的、已灭菌培养皿;装有LB液体培养基的、已灭菌的250ml三角瓶封口膜和橡皮圈酒精灯接种环镊子装有酒精棉球的广口瓶恒温培养箱摇床【操作流程】灭菌、消毒划线、接种培养、观察【实验步骤】1.接种前的准备进行接种操作前,应先洗手,再用70%的酒精棉球擦拭双手和桌面。




实验1 大肠杆菌的培养和分离教学提纲实验目的1.进行大肠杆菌的扩增,利用液体培养基进行细菌培养的操作。
2.进行大肠杆菌的分离,用固体培养基进行细菌的划线培养。
3.说明大肠杆菌的培养条件和操作要求的原理。
实验材料1.配制LB液体培养基,蛋白胨0.5g,酵母提取液0.25g,氯化钠0.5g,加水50mL溶解。
2.配制LB固体培养基,蛋白胨0.5g,酵母提取液0.25g,氯化钠0.5g,琼脂1g,加水50mL溶解(配制LB固体培养基是用来倒平板和倒试管斜面)。
实验步骤1.培养基灭菌。
在两个150mL的三角瓶中分别装入50mL LB液体培养基和50mL LB固体培养基(刚配好,尚未凝固),加上封口膜(一种塑料薄膜,中间有小孔的滤膜。
既可以通气,又不使细菌进入。
)。
将培养皿用牛皮纸包好,放入高压灭菌锅中,1kg压力灭菌15min(有压力时开始计时)。
同时将需要灭菌使用的培养皿、试管、三角瓶等和所用器械(接种环、镊子等)等一块灭菌。
2.倒平板,倒斜面。
灭菌后。
待高压锅压力与大气压相同时,打开锅盖,将有培养基的三角瓶、试管、培养皿等放在灭菌后的超净工作台上。
超净工作台操作:打超净工作台的紫外灯(注意:打开紫外灯后人必须离开),持续30min,关闭紫外灯,打开过滤风和白炽灯。
将有培养基的三角瓶和培养皿放在灭菌后的超净工作台上后,点燃酒精灯,用镊子夹出酒精棉球擦拭桌面,并用酒精棉球擦手。
待固体培养基冷却到60℃时(手放上还有些热的时候),在酒精灯火焰旁,以右手无名指及小指夹持含有固体培养基的三角瓶的封口膜,右手其他三个手指拿着三角瓶;左手拿着培养皿,并打开上盖的一边,将三角瓶的培养基约10~20mL倒入1 个培养皿中。
倒入后立即置于水平位置上,轻轻摇晃,使培养基铺满培养皿底,待凝,使之形成平面。
倒斜面(试管内空白斜面),用玻璃漏斗倒入试管内,每试管2mL。
试管斜靠在平放的铅笔上,冷却凝固。
3.液体培养基用于大肠杆菌的扩大培养。

实验1,大肠杆菌的培养和分离篇一:实验1 大肠杆菌的培养和分离实验教学提纲实验1 大肠杆菌的培养和分离教学提纲实验目的1. 进行大肠杆菌的扩增,利用液体培养基进行细菌培养的操作。
2. 进行大肠杆菌的分离,用固体培养基进行细菌的划线培养。
3. 说明大肠杆菌的培养条件和操作要求的原理。
实验材料1. 配制LB液体培养基,蛋白胨0.5g,酵母提取液0.25g,氯化钠0.5g,加水50mL溶解。
2. 配制LB固体培养基,蛋白胨0.5g,酵母提取液0.25g,氯化钠0.5g,琼脂1g,加水50mL溶解(配制LB固体培养基是用来倒平板和倒试管斜面)。
实验步骤1. 培养基灭菌。
在两个150mL的三角瓶中分别装入50mL LB液体培养基和50mL LB 固体培养基(刚配好,尚未凝固),加上封口膜(一种塑料薄膜,中间有小孔的滤膜。
既可以通气,又不使细菌进入。
)。
将培养皿用牛皮纸包好,放入高压灭菌锅中,1kg压力灭菌15min(有压力时开始计时)。
同时将需要灭菌使用的培养皿、试管、三角瓶等和所用器械(接种环、镊子等)等一块灭菌。
2. 倒平板,倒斜面。
灭菌后。
待高压锅压力与大气压相同时,打开锅盖,将有培养基的三角瓶、试管、培养皿等放在灭菌后的超净工作台上。
超净工作台操作:打超净工作台的紫外灯(注意:打开紫外灯后人必须离开),持续30min,关闭紫外灯,打开过滤风和白炽灯。
将有培养基的三角瓶和培养皿放在灭菌后的超净工作台上后,点燃酒精灯,用镊子夹出酒精棉球擦拭桌面,并用酒精棉球擦手。
待固体培养基冷却到60℃时(手放上还有些热的时候),在酒精灯火焰旁,以右手无名指及小指夹持含有固体培养基的三角瓶的封口膜,右手其他三个手指拿着三角瓶;左手拿着培养皿,并打开上盖的一边,将三角瓶的培养基约10~20mL倒入1 个培养皿中。
倒入后立即置于水平位置上,轻轻摇晃,使培养基铺满培养皿底,待凝,使之形成平面。
倒斜面(试管内空白斜面),用玻璃漏斗倒入试管内,每试管2mL。



.实验1:大肠杆菌的培养和分离一、教学要求二、基本内容1.培养基的种类和化学成份培养基的种类有很多划分标准,按物理性质分:固体培养基和液体培养基(加入琼脂多少)。
液体培养基用于扩大培养和工业生产,固体培养基用于菌种分离,鉴定,计数(菌落数量)。
培养基的化学成分包括水、无机盐、碳源、氮源、生长因子等。
按照微生物的同化作用类型是自养还是异养,碳源不同,自养微生物为无机碳源,如硝化细菌是二氧化碳或碳酸盐,异养微生物为有机碳源,如大肠杆菌是葡萄糖等有机物。
2.常见微生物类群原核生物(如细菌大肠杆菌――二分裂、革兰氏阴性、异养兼性厌氧性肠道杆菌、蓝藻、支原体、衣原体、放线菌等)、原生生物(草履虫、变形虫等)、真菌(酵母菌――出芽生殖.异养兼性厌氧性微生物、霉菌、食用菌)、病毒等。
细菌是单细胞的原核生物,有细胞壁(肽聚糖)、细胞膜、细胞质,无成型的细胞核,只有一环状DNA分子(拟核)。
以分裂(二分裂)的方式繁殖,分裂速度很快。
用革兰氏染色法将细菌分为革兰氏阳性菌(革兰氏染液染色后,再脱色处理,细菌仍保留染色液的颜色)和革兰氏阴性菌两大类,区别在细胞壁的成分不同。
大肠杆菌是革兰氏阴性(细胞壁薄,有荚膜)、兼性厌氧的肠道杆菌。
3.无菌技术对实验操作空间、操作者的衣着和手进行清洁和消毒;将培养器皿、接种用具和培养基等器具进行灭菌;为避免周围微生物污染,实验操作应在酒精灯火焰附近旁进行;避免已灭菌处理的材料用具与周围物品相接触。
灭菌方法:。
灼烧灭菌法①接种环、接种针、试管口等使用..②玻璃器皿、金属用具等使用干热灭菌法,所用器械是干热灭菌箱。
③培养基、无菌水等使用高压蒸汽灭菌法,所用器械是高压蒸汽灭菌锅。
④表面灭菌和空气灭菌等使用紫外线灭菌法,所用器械是紫外灯。
4.培养基的配制原则目的要明确:根据培养的微生物种类、培养的目的等确定培养基的类型和配制量。
营养要协调:培养基中各种营养物质的浓度和比例要适宜。
pH要适宜:细菌培养基pH中性或偏碱性,霉菌培养基呈酸性。
实验1 大肠杆菌的培养和分离高二年级班姓名学号:实验日期:____月日【知识准备】1.背景知识:大肠杆菌(Escherichia coli,E.coli)是微生物学和遗传学常用的实验材料,为单细胞原核生物,宽约0.5×1~3微米;具有由肽聚糖组成的细胞壁;周身具鞭毛,能运动。
大肠杆菌是在人和动物肠道中生活的、不会致病的正常栖居菌,但若进入胆囊、膀胱等处也会引起炎症。
它能利用多种糖类物质产酸、产气,其代谢类型为异养兼性厌氧型;其代谢活动能产生大肠杆菌素(抑制肠道内其他分解蛋白质的微生物生长),还能合成维生素B和K。
它们在肠道中大量繁殖,几乎占粪便干重的1/3。
实验室中用于培养微生物的营养物质称为培养基。
按培养基的物理状态可分为:液体培养基和固体培养基。
将已知的菌种引入新配制的培养基的过程称为接种。
而在固体培养基表面用蘸有菌种的接种环连续划线,既可以达到接种的目的,又可以实现分离菌种的目的。
这是因为划线过程中接种环与培养基表面接触,接种环上的菌液逐渐减少,因此划线最后部分细菌间的距离加大,经过培养后可出现由单个细菌细胞形成单菌落,这样就达到了分离细菌的目的。
2.实验原理:使用通用的细菌培养基(如LB液体培养基)可扩大培养大肠杆菌,使大肠杆菌迅速扩增。
在LB固体平面培养基上对大肠杆菌进行划线分离,经培养后培养基上每一个菌体会形成一个单独的菌落。
这是消除污染杂菌的通用方法,也是用于筛选突变菌株的最简便方法之一。
为保证配制的培养基上只生长大肠杆菌,而不被其他微生物污染,实验过程中要进行无菌操作。
3.思考题(1)为什么培养过程中会出现被其他微生物污染的现象?(2)进行了无菌操作是否肯定就不会出现被其他微生物污染的现象吗?(3)本实验的关键步骤——划线分离的目的是什么?(4)在做第二次以及其后的划线操作时,为什么总是从上一次划线的末端开始划线?在操作过程中应注意什么?【实验目的】1.利用液体培养基进行大肠杆菌的扩增2.用固体平面培养基进行大肠杆菌的划线分离3.了解微生物实验的操作原理和培养条件【材料用具】大肠杆菌菌种装有固体培养基的、已灭菌培养皿;装有LB液体培养基的、已灭菌的250ml三角瓶封口膜和橡皮圈酒精灯接种环镊子装有酒精棉球的广口瓶恒温培养箱摇床【操作流程】灭菌、消毒划线、接种培养、观察【实验步骤】1.接种前的准备进行接种操作前,应先洗手,再用70%的酒精棉球擦拭双手和桌面。